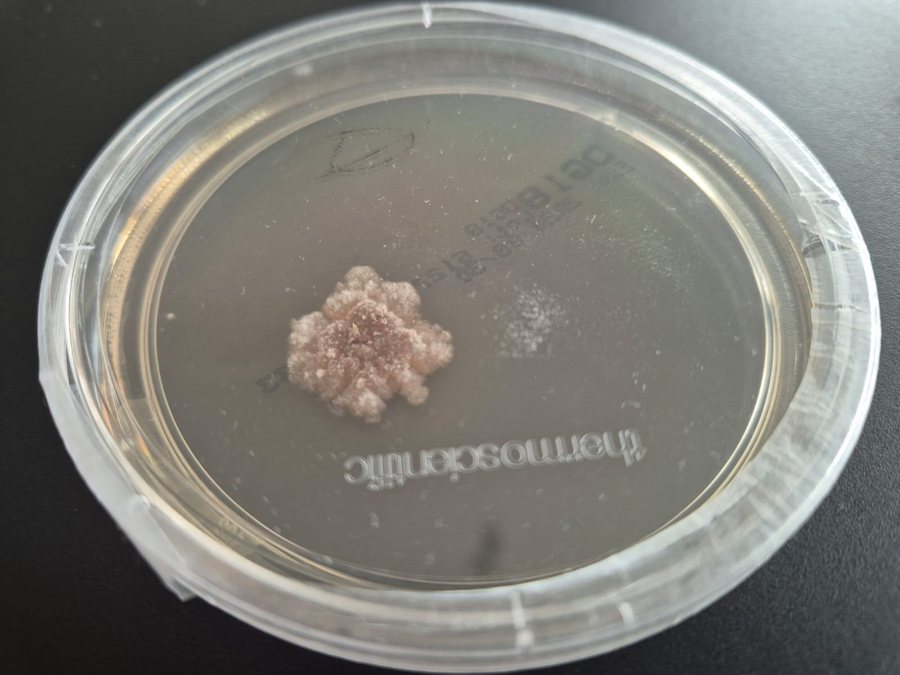

Wir sind Ihre Schimmelgutachter und Bausachverständige für Alzenau
Dekra-Zertifiziert, unabhängig und erfahren. Wir sind für Sie da, rufen Sie uns an!
Unser Büro bietet Ihnen ein breites Spektrum an professionellen Bausachverständigen-Dienstleistungen, die von Schimmelpilz – Bewertung, Analyse von Feuchteschäden bis hin zu Gutachtenerstellung reichen. Mit unserer langjährigen Erfahrung und modernster Technik sorgen wir dafür, dass Ihre Immobilie in bestem Zustand bleibt und mögliche Probleme frühzeitig erkannt und behoben werden.
Wir arbeiten sorgfältig und zuverlässig, um die Sicherheit und den Werterhalt Ihrer Gebäude zu gewährleisten. Vertrauen Sie auf unsere Expertise und lassen Sie uns gemeinsam die optimale Lösung für Ihre baulichen Herausforderungen finden. Kontaktieren Sie uns noch heute und profitieren Sie von unserer umfassenden Beratung und unserem erstklassigen Service in Alzenau.
Bei diesen und weiteren Themen sind wir für Sie da.
Um Schimmelpilze präzise bestimmen zu können und die passenden Sanierungsmaßnahmen einzuleiten, auch um z.B. gesundheitliche Bedenken vermeiden bzw. Ursachen dafür beseitigen zu können, sind grundsätzlich Probenahmen bzw. ausführliche Untersuchungen und Messmethoden erforderlich, die von uns ins enger Zusammenarbeit mit einem renommierten Labor ausgewertet werden.
Feuchtigkeitsmessung in Alzenau

Das ist entscheidend, um potenzielle Schäden durch Wassereinwirkung frühzeitig erkennen zu können und die Schadensursache schnell zu beseitigen. Außerdem ist dies notwendig, um um Schimmelbildung bzw. strukturelle Schäden ausschließen zu können.
Thermografiegutachten in Alzenau

Identifikation von Schadensursachen. Unabdingbar für Qualitätssicherung, Werterhaltung und gesundes Wohnklima. Angepasst an Ihre ganz individuellen Anforderungen und Objektbedingungen.
Laborergebnisse / Auswertung in Alzenau

Wir leisten die professionelle Auswertung der Laborergebnisse, einschließlich detaillierter Analyse und Interpretation gemäß neuester Standards. Unsere Leistungen umfassen die Prüfung der Rohdaten und Erstellung eines präzisen Berichts mit klaren Handlungsempfehlungen.
Mikrobiologische Untersuchung in Alzenau
Notwendig, um Schimmelpilze bzw. einen Schädlingsbefall präzise bestimmen zu können. Auch, um gesundheitliche Bedenken bzw. Schäden für die Bausubstanz vermeiden zu können, sind grundsätzlich Probenahmen erforderlich, die von einem renommierten Labor in Berlin ausgewertet werden.
Für die Sammlung der Proben nutzen wir unter anderem:
– Abstrichproben
– Klebefilmproben
-Abklatschproben
Luftkeimmessung und Partikelsammlung in Alzenau

Die Luftkeimmessung eignet sich besonders bei verstecktem und unsichtbarem Schimmelbefall.
Hierbei wird die Luft durch spezielle Lochimpaktoren geleitet, um Schimmelsporen zu sammeln. Die Luft strömt auf eine darunter befindliche Sammelfläche und kann dann im Labor ausgewertet werden.
Antworten auf häufig gestellte Fragen
Was sind Schimmelpilze?
Schimmelpilze, häufig einfach als Schimmel bezeichnet, sind eine vielfältige Gruppe fadenförmiger Pilze. In der Mikrobiologie werden sie systematisch zu einer heterogenen Gruppe von Pilzen (Fungi) gezählt. Heterogen bedeutet, dass die Bestandteile dieser Gruppe uneinheitlich sind, während „taxonomisch“ auf ihre Einordnung in ein spezifisches System hinweist.
Was sind Schimmelpilzquellen ? Was sind deren Auswirkungen?
Von einer Schimmelpilzquelle können verschiedene Partikel wie Sporen, Myzel (Pilzgeflecht), Myzelbruchstücke, Hyphen (Pilzfäden), Hyphenbruchstücke sowie Zellbestandteile und Stoffwechselprodukte freigesetzt werden. Zu den Stoffwechselprodukten gehören Beta-Glukane, Ergosterol, Toxine und flüchtige organische Verbindungen (MVOC). Diese können allergische Reaktionen und andere gesundheitliche Probleme verursachen.
Wie ist die Lebensweise und die Gefahren von Schimmelpilzen?
Viele Schimmelpilze sind Saprophyten, das heißt, sie ernähren sich von abgestorbenem organischem Material. Nur ein kleiner Teil der zahlreichen Schimmelpilzarten, etwa 150 Arten, kann parasitär leben und andere Organismen, einschließlich Menschen, schädigen. Diese pathogenen Schimmelpilze betreffen hauptsächlich immunsupprimierte Personen, deren Immunsystem geschwächt ist. Gesunde Menschen sind in der Regel nicht gefährdet, da ihr Immunsystem die Keimung der Sporen verhindert.
Wenn jedoch das Immunsystem einer Person stark geschwächt ist, können sich Schimmelpilze im Körper ausbreiten und ernsthafte Erkrankungen, sogenannte Mykosen, verursachen. Diese treten besonders bei Personen mit Vorerkrankungen wie Asthma, Tuberkulose, chronischer Bronchitis, Hepatitis, Nierenerkrankungen, Anämie, Autoimmunerkrankungen und anderen gesundheitlichen Problemen auf.
Wie kann der Schimmelpilz in den menschlichen Körper Eindringen und sich Ausbreiten?
Um eine Erkrankung auszulösen, müssen Schimmelpilze effizient in den menschlichen Organismus eindringen. Dies geschieht oft durch das Einatmen von Sporen, die bis in die Lungenbläschen vordringen und dort auskeimen können – vorausgesetzt, der Körper ist dafür empfänglich.
Deshalb sollte immer sofort versucht werden den Schimmelpilzbefall klar zu definieren bzw. zu bestimmen welche Art bzw. Gattung vorliegt und entsprechende Maßnahmen einleiten.
Können Schimmelpilze Materialschäden verursachen ?
Schimmelpilze können durch ihre Besiedlung und ihren komplexen Stoffwechsel unter geeigneten Bedingungen verschiedene Materialien schädigen oder zerstören. Die wichtigste Voraussetzung dafür ist das Vorhandensein von Feuchtigkeit. Schimmelpilze können eine Vielzahl von Nährstoffen nutzen und werden in drei Gruppen von Materialzerstörern unterteilt.
Wie kann bei Feuchtigkeit und Schimmelpilzen eine Ursachenanalyse betrieben werden?
Um Feuchtigkeits- und Schimmelprobleme zu diagnostizieren, ist eine gezielte Analyse notwendig. Dabei werden die spezifischen Eigenschaften eines Gebäudes und das Verhalten der Bewohner berücksichtigt. Klimadatenaufzeichnungen, beispielsweise mit Datenloggern, sind ein nützliches Verfahren, um Temperatur- und Feuchtigkeitsverläufe zu analysieren. Auch die Aufzeichnung von Wandoberflächentemperaturen und CO2-Konzentrationen in der Luft kann hilfreich sein, um die Situation besser bewerten zu können
Durch eine gezielte Prävention und rechtzeitige Maßnahmen können Feuchtigkeits- und Schimmelprobleme effektiv vermieden oder behoben werden. Eine regelmäßige Kontrolle der Feuchtigkeitswerte und eine gute Belüftung sind hierbei entscheidend.

Jörg Aichinger
Dekra-geprüfter Bausachverständiger,
Büroinhaber
Das sagen unsere Kunden
„Kompetent, freundlich und Gold wert“
Wir sind auf Herrn Aichinger über den Bauherren-Schutzbund im Rahmen der baubegleitenden Qualitätskontrolle als unabhängigen Bauherren-Berater aufmerksam geworden.
Er wies zu Vor-Ort-Terminen bei relevanten Baustufen (immer dann, wenn durch nicht entdeckte Mängel gravierende Folgen entstehen können) gegenüber unserer Bauleitung mittels eines Baustellenberichts kompetent auf potentielle „Fehler“ hin und verfolgte die korrekte Ausführung immer zeitnah nach. Hinsichtlich Argumentation zu den physikalischen Auswirkungen auf den Baukörper war er als Sachverständiger für uns Gold wert, da wir als Laien schwere Baumängel gar nicht erkennen hätten können, geschweige denn ernst genommen worden wären. Auch unser Fertighausanbieter reagierte immer zügig auf die gelisteten Themen von Herrn Aichinger.
Alles in allem sind wir sehr zufrieden und würden uns jederzeit wieder für ein baubegleitendes Qualitätscontrolling durch Herrn Aichinger & Team entscheiden.
– André S. über Google
„Sehr zufrieden“
Ich bin sehr zufrieden, die Firma ist nur zu Empfehlen, jederzeit wieder, Herr Aichinger ist sehr kompetent, es gab nie Probleme.
– Siegfried R., über MyHammer


